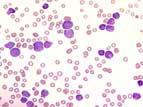

Kurzbeschreibung:
Die akute lymphoblastische Leukämie (ALL) ist die typische Leukämie des Kindesalters mit einer Häufung zwischen dem zweiten und fünften Lebensjahr. Eine zweite Häufung kann im höheren Alter beobachtet werden. Die leukämischen Blasten verdrängen das blutbildende Knochenmark und infiltrieren Lymphknoten, Milz, Leber und andere Organe. Ohne Therapie ist die Überlebenszeit sehr kurz. Verschiedene zytostatische Therapieformen führen jedoch bei den meisten Patienten zu einer Remission. Die Heilungschancen sind heute vor allem bei der kindlichen ALL sehr gut.
Klinisches Bild:
Die Krankheit setzt abrupt ein und verläuft rasch progredient. Die Symptome sind vornehmlich auf die infiltrationsbedingte Knochemarksinsuffizienz mit Neutropenie, Anämie und Thrombozytopenie zurückzuführen. Entsprechend treten Schwäche, Blässe, Fieber und Hautblutungen auf. Hinzu kommen noch Reizbarkeit, Appetit- und Gewichtsverlust sowie Knochen- und Gelenksschmerzen. Eine Vergrösserung der Milz, der Leber und der Lymphknoten ist häufig. Gelegentlich bestehen Zeichen einer ZNS-Beteiligung mit Kopfschmerzen und Erbrechen. Vor allem bei der T-lymphoblastischen Leukämie findet sich oft eine grosse mediastinale Tumormasse (bulk).
Hämatologie:
Bei rund 50% der Patienten besteht eine zum Teil sehr ausgeprägte Leukozytose mit Neutropenie. Die Blasten sind meist klein, mit schmalem Zytoplasmasaum, verschwommenem Chromatin und fehlenden oder nur schlecht erkennbaren Nukleolen. Die zytochemische Peroxidase- udn Esterasefärbung ist komplett negativ. Eine zytologische Unterscheidung zwischen akuten B- und T-lymphoblastischen Leukämien ist nicht möglich. Die normochrom-normozytäre Anämie kann sehr ausgeprägt sein.
Knochenmark:
Das Knochenmark ist meist hyperzellulär mit dichter Infiltration durch eher kleine, ungranulierte Blasten. In den zytochemischen Spezialfärbungen fallen die Peroxidase und die Esterase negativ aus.
Klassifikation:
Die akuten lymphoblastischen Leukämien werden von der WHO 2008-Klassifikation gemäss der postulierten Abstammung von unreifen lymphatischen Vorläufern als lymphatische Vorläuferzell-Neoplasien bezeichnet. Dies soll die Abgrenzung von den reifzelligen lymphatischen Neoplasien (Lymphomen) betonen. Die akuten lymphoblastischen Leukämien können sowohl die B-Zellreihe (B-ALL) wie die T-Zell-Reihe (T-ALL) betreffen. In Analogie zu den akuten myeloischen Leukämien werden akute B-lymphoblastische Leukämien mit wiederkehrenden genetischen Aberrationen und charakteristischem biologischem Verhalten von der WHO 2008-Klassifikation separat aufgeführt. Während die akuten lymphoblastischen Leukämien dem Namen gemäss "leukämisch" verlaufen, können sich lymphoblastische Prozesse auch auf Lymphknoten oder extramedulläres Gewebe beschränken. Man spricht dann von akuten lymphoblastischen Lymphomen, wobei sich diese bezüglich Krankheitsverlauf nicht von den akuten lymphoblastischen Leukämien unterscheiden.
Diagnostik:
Bei der Klassierung der akuten lymphoblastischen Leukämien spielt die durchflusszytometrisch Immunphänotypisierung eine herausragende Rolle, da nur diese eine rasche Linienzuordnung und sichere Abgrenzung von den akuten myloischen Leukämien erlaubt. Zytogenetik und molekularbiologische Untersuchungen sind zur diagnostischen Einteilung und prognostischen Risikoabschätzung ebenfalls sehr wichtig.